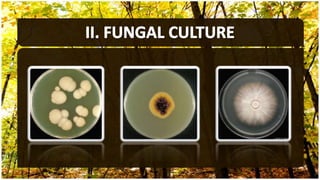

The document discusses dermatophyte infections, which affect superficial keratinized structures in the skin, hair, and nails, emphasizing three main genera: Trichophyton, Epidermophyton, and Microsporum. It outlines various clinical presentations, such as tinea capitis, tinea corporis, and tinea pedis, along with their causes, symptoms, and treatment considerations. Factors influencing infection include immune status, body location, and the type of dermatophyte, with descriptions of typical patterns of infection and response to treatment.








![• Etymology: L. [caput] head.
• Tinea capitis is the most common pediatric dermatophyte
infection worldwide.
• The age predilection (3 and 7 years of age) is believed to
result from the presence of Malassezia furfur which is part of
normal flora, and from the fungistatic properties of fatty
acids of short and medium chains in postpubertal sebum so
it is rare in adult population.](https://image.slidesharecdn.com/fungalinfectionspartiii-141205163142-conversion-gate02/85/Fungal-infections-part-III-9-320.jpg)